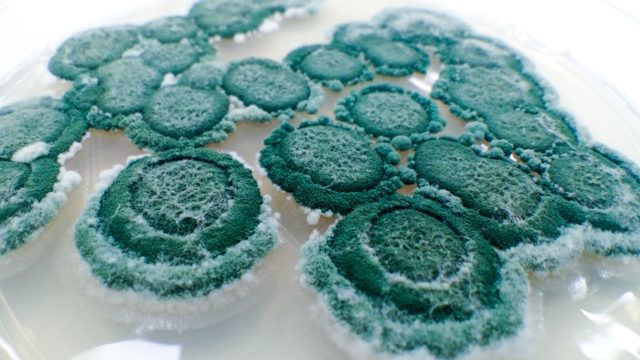

Luciano Olmos Zappelini
Gerente de Produção e Desenvolvimento da Koppert do Brasil

O uso de Trichodermaharzianum vem se consagrando nos sistemas agrícolas brasileiros nos últimos dez anos, muito em função da obtenção do primeiro produto registrado no Brasil à base do fungo Trichodermahazianum como fungicida microbiológico, obtido pela Koppert no ano de 2007.
Os dados de campo do Trichodermil SC 1306 celebram a excelência do produto na redução e controle de diferentes alvos, como Fusarium (podridão), Rhizoctonia (mela ou tombamento) e Sclerotinia (mofo branco) para diversas culturas, desde grãos, gramÃneas até HF.
Seu modo de ação ocorre de maneiras distintas, dentre elas pelo controle de fungosfitopatogênicos, uma vez que o Trichoderma possui alta competência em colonizar solos e sistemas radiculares. Isso, primeiramente, propicia ao fungo a ocupação dos sÃtios de infecção e, por consequência, a produção de metabólitos, enzimas (substâncias voláteis) que são liberadas pelo Trichoderma, gerando uma barreira química aos fitopatógenos.
Também desencadeiam nas plantas uma resposta fisiológica à produção de fitohormônios, o que diretamente maximiza o potencial produtivo das culturas, caracterizando assim a ação de promoção de crescimento de plantas. O Trichoderma ainda possui a capacidade de parasitar escleródios e hifas de fungos causadores de doenças no solo, inviabilizando-os e contribuindo significativamente para a redução da incidência de doenças. A solubilização de nutrientes no solo, tornando-os disponíveis às plantas, também é atribuÃda à ação do Trichoderma na rizosfera.

Inovação
Por meio de muita inovação em pesquisa frente aos diferentes modos de ação do agente biológico de controle Trichodermaharzianum, cepa 1306, constatou-se que alguns metabólitos ou enzimas possuem ação direta sobre populações de nematoides fitopatogênicos, dentre eles o Pratylenchuszeae (nematoide das lesões).
Desde então, a Koppert dedicou-se à condução de repetidos campos experimentais, bem como ensaios de praticabilidade agronômica contra o alvo Pratylenchuszeae acarretou na inclusão deste no registro do produto Trichodermil SC 1306, passando para fungicida e nematicida microbiológico por meio da aprovação do Ministério da Agricultura Pecuária e Abastecimento (MAPA) desde setembro de 2017.
Sendo assim, além de todos os já conhecidos benefícios e vantagens da utilização desta moderna ferramenta, o produto Trichodermil SC 1306 passa a ter dupla ação (fungicida e nematicida microbiológico) na cultura da cana-de-açúcar, combatendo diretamente fungos e nematoides fitopatogênicos.